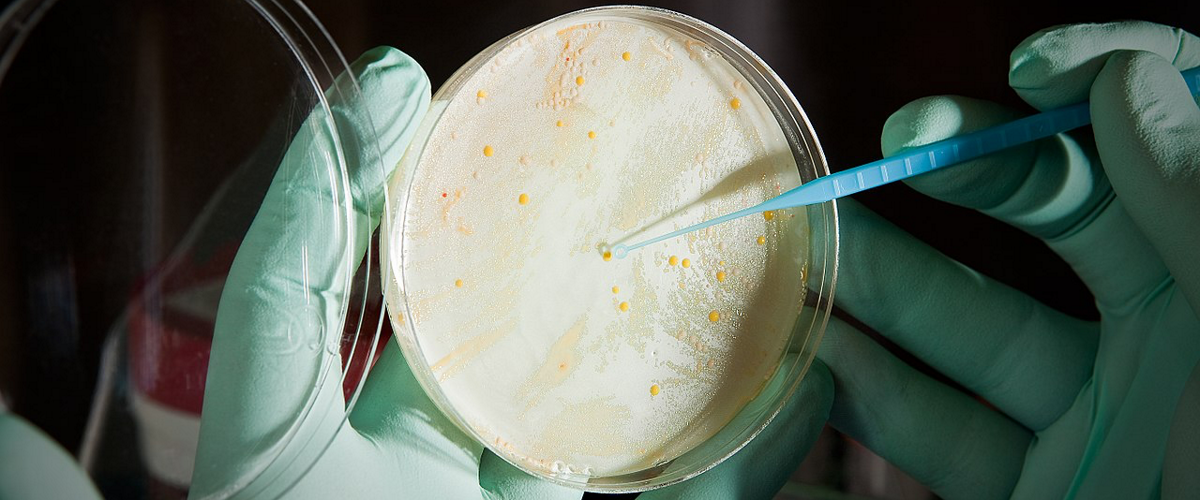
image

Pro-AG: CRISPR против супербактерий и устойчивости к антибиотикам
Знаете, что меня по-настоящему пугает? Это не монстры из фильмов ужасов, а крошечные существа, которых мы даже не видим. Я говорю об бактериях, которые учатся игнорировать наши лекарства. Устойчивость к антибиотикам – это тихая глобальная угроза, и прогнозы звучат апокалиптически: к середине века она может уносить до 10 миллионов жизней в год. Но что, если у нас появился крошечный, но невероятно точный союзник? Исследователи из Калифорнийского университета в Сан-Диего взяли на вооружение систему CRISPR и создали умное оружие против супербактерий.
Они назвали его Pro-AG. Представьте себе молекулярного хирурга с ножницами. Именно так работает классический CRISPR-Cas9: он находит проблемный ген и вырезает его. Pro-AG использует похожий принцип, но его задача — не просто разрезать, а обезвредить врага.
«По сути, мы используем Pro-AG, чтобы вывести из строя тот самый ген, который делает бактерию неуязвимой для антибиотика», — поясняют ученые. Элегантно, не правда ли?
Главная головная боль — это плазмиды. Это такие хитрые кольца ДНК, которые болтаются внутри бактерии отдельно от её основной хромосомы. И они как раз и содержат гены устойчивости. Проблема в том, что этих копий может быть десятки, и пока вы боретесь с одной, другие продолжают работу. Pro-AG атакует именно их, решая одну из самых острых проблем резистентности.
Лабораторные тесты на кишечной палочке, нашпигованной такими плазмидами, показали, что инструмент бьёт точно в цель. Устойчивые гены переставали работать. Это многообещающий результат, хотя путь от чашки Петри до клиники ещё долог.
Но потенциал захватывает дух! Представьте лечение хронических инфекций, которые сегодня буквально изматывают пациентов: упрямые инфекции мочевыводящих путей, туберкулез или те самые биопленки, которые образуют бронированную крепость для бактерий. Pro-AG мог бы стать ключом к их разрушению. Работа, безусловно, будет продолжена.
И кстати, CRISPR не останавливается на бактериях. Совсем недавно учёные применили этот метод для атаки на вирус герпеса. Самое впечатляющее — система смогла найти и обезвредить даже «спящие», скрытые копии вируса в клетках. Похоже, мы стоим на пороге целой новой эры в борьбе с инфекциями.










